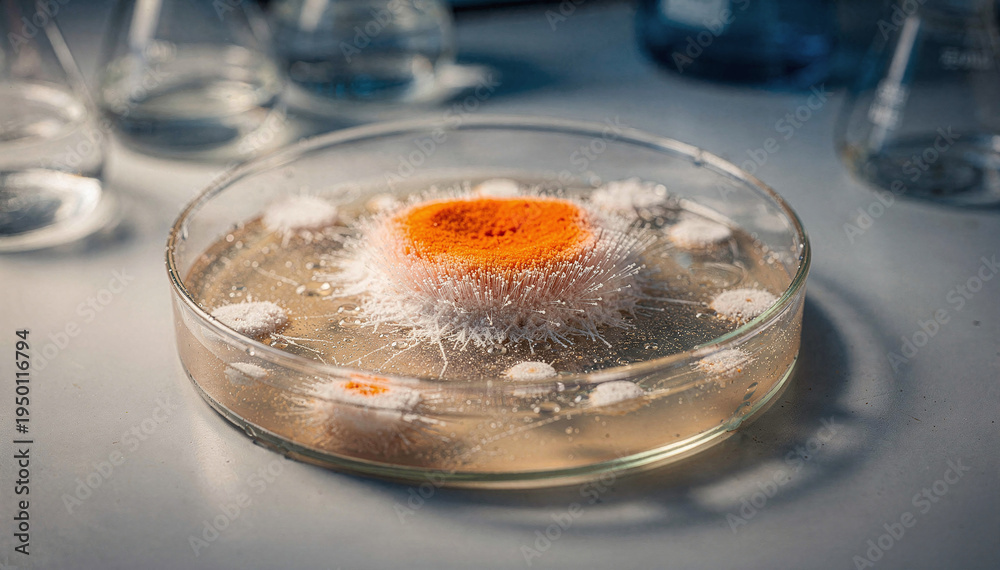

Ningún producto
Estos precios se entienden IVA incluído
Se ha añadido un nuevo artículo a tu cesta.
0 Artículos en su carrito. 1 Artículo en su carrito.
Tu foto en un lienzo lucirá como una obra de arte gracias a las tintas ecosolventes y la alta resolución que ofrecemos en nuestro productos.
Los lienzos de fotos son un formato elegante que permite acabados profesionales para las imágenes que más te gusten, y que podrás colocar en cualquier pared de tu casa.
Si lo que te gustan son las imágenes sobre tela, esta es tu opción. El foto lienzo cuenta tela montada sobre un marco de madera.
Para crear tu foto lienzo personalizado puedes tanto escoger una imagen propia, como elegir una de imagen de nuestro banco.
Los tamaños de las fotos en lienzo personalizadas de Rotulatumismo van desde 20 x 30 cm hasta 160 x 120 cm.
El foto lienzo se imprime en tela canvas de alta calidad, imitando así la tela de los lienzos artísticos.
El montaje en bastidor es de 35mm de ancho con una alta resolución.
Los cuadros de lienzo están disponibles en varios formatos:
El lienzo con foto personalizada te ofrece varias opciones en cuanto a efectos:
Colgar tus cuadros con lienzo es realmente fácil. Simplemente necesitarás acoplar los colgadores del lienzo y clavarlo sobre la pared de tu casa deseada.
¡Consigue tu foto lienzo barato en Rotulatumismo!
Lienzo impreso con tu foto con bastidor de 3.5 cm. ¿Quieres hacer un regalo a una persona especial? ¿Quieres decorar un rincón de tu casa con un momento importante? Nosotros te ofrecemos poder hacerlo con nuestros foto lienzos de alta calidad por un precio muy económico. En nuestro taller los foto lienzos se imprimen con tintas ecosolventes y de una alta resolución.
No lo dude más y compre con nosotros su foto lienzo.
Lienzos impresos con tu foto para colgar en la pared.
1-Escoge tu foto
2-Súbela a nuestra web
3-recibe en 5 días laborables tu lienzo en casa.
Fabricación española con bastidores de madera y tintas de alta calidad resistentes al sol. Nuestras tintas son tintas de exterior, por lo que si está cerca de una ventana, las tintas aguantarán hasta 3 años con exposición directa a los rayos UV.
Conoce el resto de nuestro catálogo de cuadros personalizados